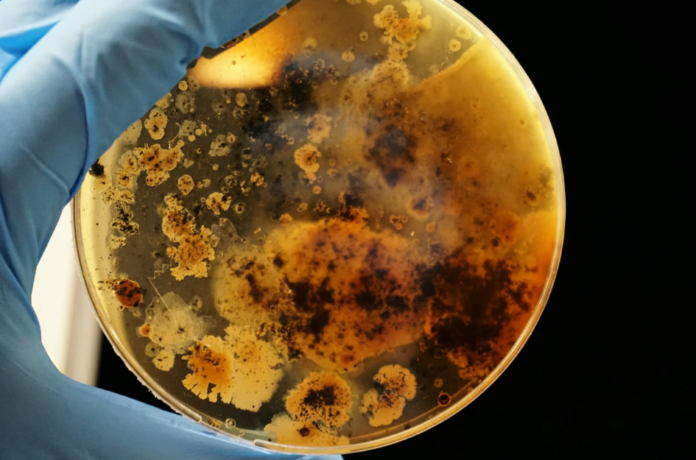

Βακτήρια που προκαλούν σπάνια και θανατηφόρα λοίμωξη εντοπίστηκαν στον Μισισιπή
Οι αμερικανικές υγειονομικές αρχές ανακοίνωσαν ότι σε δειγματοληψίες εδάφους και νερού από τον Μισισιπή ανιχνεύθηκαν βακτήρια που προκαλούν μια σπάνια αλλά σοβαρή ασθένεια, τη μελιοείδωση.
Οι αρμόδιες αρχές συνέστησαν στους γιατρούς της χώρας να είναι προσεκτικοί απέναντι σε πιθανά συμπτώματα της λοίμωξης σε ασθενείς.
Δύο κάτοικοι στις νότιες αμερικανικές πολιτείες, στην περιοχή του Κόλπου του Μεξικού, μολύνθηκαν το 2020 και το 2022, υποχρεώνοντας τους ειδικούς των Κέντρων Ελέγχου και Πρόληψης Ασθενειών (CDC) να προβούν σε δειγματοληψίες.
Σε τρία δείγματα ανιχνεύθηκε το βακτήριο Burkholderia pseudomallei (Ψευδομονάδα της ψευδομάλεως).
Ωστόσο, τα CDC θεωρούν ότι ο κίνδυνος για τον πληθυσμό παραμένει «πολύ χαμηλός». Επί του παρόντος, ερευνούν κατά πόσο είναι διαδεδομένα τα συγκεκριμένα βακτήρια στο περιβάλλον.
Τα συμπτώματα της μελιοείδωσης περιλαμβάνουν πυρετό, πόνο στις αρθρώσεις και πονοκέφαλο. Μπορεί να προκαλέσει πνευμονία, σχηματισμό αποστημάτων και διάφορες λοιμώξεις. Παγκοσμίως, η μελιοείδωση είναι θανατηφόρα στο 10-50% των περιπτώσεων.
Συνιστάται σε όσους ανήκουν στις λεγόμενες ευπαθείς ομάδες του πληθυσμού στον Μισισιπή να αποφεύγουν την επαφή με βρώμικα νερά, να προστατεύουν τυχόν πληγές τους και να φορούν αδιάβροχες μπότες και γάντια κατά την κηπουρική.
Περίπου 12 κρούσματα μελιοείδωσης καταγράφονται κάθε χρόνο στις Ηνωμένες Πολιτείες, κυρίως σε ταξιδιώτες που επιστρέφουν από χώρες όπου το βακτήριο είναι ενδημικό (σ.σ. κυρίως την Ινδία και άλλες χώρες της νοτιοανατολικής Ασίας), ειδικά σε τροπικές περιοχές. Ορισμένα κρούσματα έχουν επίσης αποδοθεί σε εισαγωγή προϊόντων από αυτές τις χώρες.
Με πληροφορίες από ΑΠΕ-ΜΠΕ, AFP